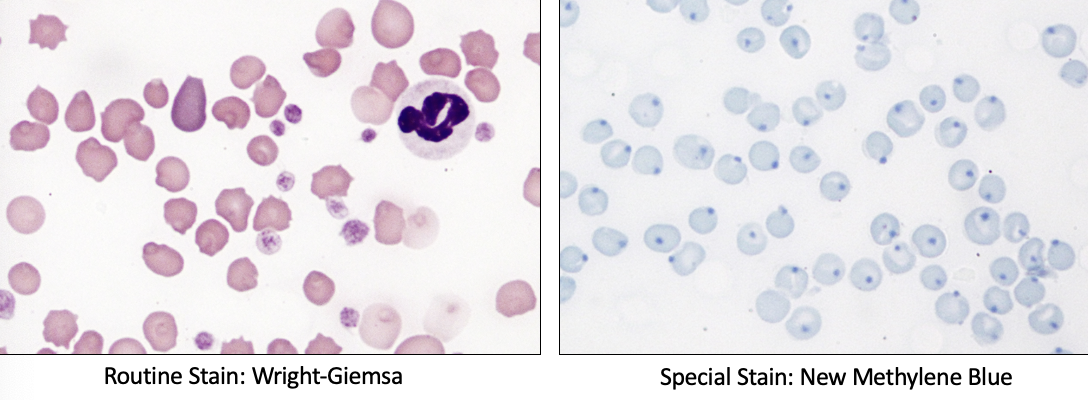
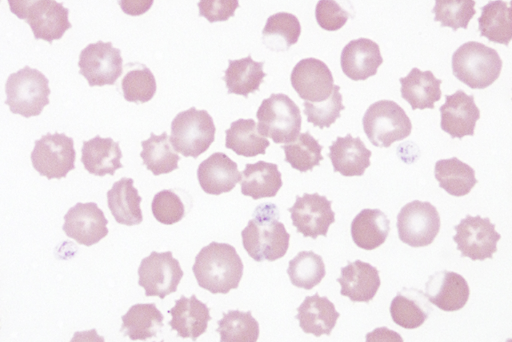

microchromic microcytic in anemia pattern
external chronic hemorrhage
iron deficiency
where can bilirubin be conjugated in the dog?
kidneys and hepatocyte
normal for dog to have a little bilirubin in urine
hemolytic anemia bilirubin metabolism
- macrophages on overdrive killing RBCs
- hepatocytes cannot keep up and conjugate all the bilirubin
- causes increase in unconjugated bilirubin in blood
fasting hyperbilirubinemia
fats bind to hepatocytes and block bilirubin metabolism
increased unconjugated biliruben
in large animals
functional cholestasis
accumulation of bile
endotoxin interferes with excretion of conjugated bilirubin
increased conjugated bilirubin
obstructional cholestasis
bile cannot be excreted (blocked bile duct)
increased conjugated bilirubin
no anemia or regeneration
intravascular hemolysis
Site of RBC destruction: Blood vessels
Initiating processes:
* Antibodies > MAC
* RBC infectious agents
* Oxidative injury
extravascular hemolysis
Site of RBC destruction: Macrophages (sinusoidal capillaries)
Initiating processes
* Antibodies > Opsonization
* RBC infectious agents
* Oxidative injury
* Old age markers
ghost cells
intravascular hemolysis
from RBC + MAC= MAC formation
loss of hemoglobin via MACs = ghost cells

spherocytes
extracellular hemolysis
no central palor
from destruction of RBC via antibodies, opsonization
mostly used in dog (cats/horses normal RBC look like spherocytes)

hemoglobinemia
free hemoglobin in blood
can be from ruptured RBCs
causes of hemolytic anemia
immune mediated hemolytic anemia(IMHA)
infectious hemolytic anemia
oxidative hemolytic anemia
fragmentation hemolysis
immune mediated hemolytic anemia
antibodies target self RBCs
how do antibodies to self RBCs form in IMHA?
Autoimmune:
Primary (nonassociative or Idiopathic) or
Secondary (associative)
* Infection
* Neoplasms
* Drugs
Alloimmune
primary (nonassociative) IMHA clinical signs
Dogs»_space; Cats
Young to middle aged
Predisposed breeds
History & Physical Examination:
-megaly
* Lymphadenomegaly
* Splenomegaly
* Hepatomegaly
Vomiting & diarrhea (V/D)
Polyuria & polydipsia (PU/PD)
Fever
IMHA mechanism
- antibodies (IgG) against RBCs
- opsonization and agglutination
- complete or partial phagocytosis of RBCs
- aggregates of RBCs
- biliruben, hemoglobin degredation products (AAs, biliruben, iron,), spherocytes, ghost cells

IMHA blood smear
agglutination of RBCs, clumps
not rouleaux (chains of RBC, normal in horses)

infectious hemolytic anemia (associative)
Pathogenesis
* Direct RBC lysis
* Innocent bystander
* Expose hidden antigens > IMHA
Signalment
* Cat, Cattle»_space;> Dog, Horse
* Variable
History & Physical Examination
* Similar to idiopathic IMHA
* -megaly
* Lymphadenomegaly
* Splenomegaly
* Hepatomegaly
Vomiting & diarrhea (V/D)
Polyuria & polydipsia (PU/PD)
Fever
diagnosing infectious hemolytic anemia
blood smear!!
check for parasites on RBCs

diagnosing infectious hemolytic anemia
blood smear!!
check for parasites on RBCs
oxidative hemolytic anemia (associative)
Pathogenesis
* Toxin ingestion, drug administration
* Oxidative RBC injury
Signalment
* Dogs, cats, horses, sheep
History & Physical Examination
* Toxin/drug exposure
* Hemolytic anemia
* Chocolate brown blood

oxidative hemolytic anemia caused by injury to iron of hemoglobin causes what clinical finding?
methemoglobinemia
blood is brown

oxidative hemolytic anemia caused by injury to globin of hemoglobin causes what clinical finding?
heinz bodies
oxidative hemolytic anemia caused by injury to RBC membranes causes what clinical finding?
eccentrocytes
most common in horses
pinched off piece of membrane, flat clear area on side of RBC